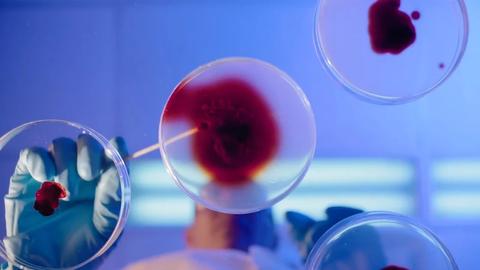

HUELLAS Y EVIDENCIAS
INVESTIGADOR CRIMINAL CARLOS ALMARZA

INTRODUCCION
En el mundo de la criminalística, existen herramientas capaces de exponer lo que el ojo humano no puede ver. Una de las más sorprendentes es el ensayo de luminol, un reactivo químico que al entrar en contacto con rastros de sangre emite un resplandor azul fluorescente en la oscuridad. Este método se ha convertido en una pieza clave en la investigación de crímenes, permitiendo descubrir evidencia oculta en la escena del delito.

PRINCIPIO QUÍMICO DEL LUMINOL.
El luminol reacciona con el hierro presente en la hemoglobina de la sangre. Al rociarlo en una superficie sospechosa y exponerlo a un agente oxidante (como el peróxido de hidrógeno), se produce una reacción química llamada quimioluminiscencia, que genera un brillo azul característico.

HISTORIA Y DESARROLLO DEL ENSAYO DE LUMINOL
Fue descubierto en 1928 por el químico alemán H. O. Albrecht, pero su aplicación en la investigación criminal se popularizó en la década de 1930. Desde entonces, ha evolucionado hasta convertirse en una técnica estándar en la investigación forense.

“La escena del crimen habla, pero solo si sabes escuchar.”

PROCEDIMIENTO DEL ENSAYO DE LUMINOL
Para preparar 1 litro de solución de luminol, se requiere la siguiente formulación
estándar:
Ingredientes:
Luminol: 0.1 g
Hidróxido de sodio (NaOH) al 5%: 5 g
disueltos en agua destilada
Peróxido de hidrógeno (H₂O₂) al 3%: 100 mL
Carbonato de sodio (Na₂CO₃): 10 g
Agua destilada: Completar hasta 1 litro
PREPARACIÓN
1.
Disolver el luminol en una pequeña cantidad de NaOH para facilitar su solubilización
2.
Agregar el carbonato de sodio y mezclar bien.
Incorporar el peróxido de hidrógeno.
4.
3. Completar con agua destilada hasta alcanzar 1 litro.
5.
Almacenar en un frasco oscuro y en un lugar fresco.

PROCEDIMIENTO PARA
REALIZAR LA PRUEBA
Se oscurece la escena del crimen.
Se rocía la solución de luminol en las áreas sospechosas.
Si hay presencia de sangre, la reacción produce una fluorescencia azul.
⚠Precaución: La solución debe prepararse en condiciones de laboratorio con el equipo adecuado, ya que el luminol es reactivo y puede degradarse con la luz.
“La evidencia no miente, pero su interpretación sí puede hacerlo.”
APLICACIONES FORENSES
El luminol ha sido clave en la resolución de crímenes al revelar sangre que había sido limpiada. Casos famosos, como el de Jeffrey MacDonald en EE.UU., utilizaron este método para descubrir pruebas ocultas. El luminol sigue siendo una herramienta fundamental en la investigación forense, permitiendo descubrir pruebas ocultas y resolver crímenes que, de otro modo, quedarían impunes.

CONCLUSIONES
El ensayo de luminol es una herramienta fascinante en la ciencia forense. Su capacidad para revelar evidencia oculta lo convierte en un aliado indispensable en la resolución de crímenes. Sin embargo, su uso debe ir acompañado de otras pruebas para garantizar resultados precisos y evitar interpretaciones erróneas.

LIMITACIONES Y FALSOS
POSITIVOS
A pesar de su eficacia, el luminol no es infalible. Sustancias como el cloro, ciertos metales y algunas verduras pueden generar falsos positivos. Además, su aplicación en sangre deteriora el ADN, lo que puede dificultar análisis posteriores.

"La evidencia no miente, el investigador debe interpretarla con precisión."